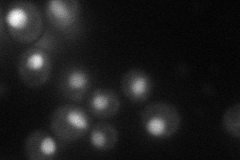
YML053C
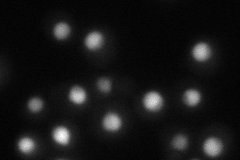
YML053C
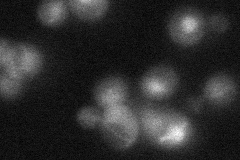
YML053C
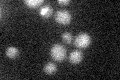
YML053C

View description
Putative protein of unknown function; green fluorescent protein (GFP)-fusion protein localizes to the cytoplasm and the nucleus; overexpression causes a cell cycle delay or arrest; YML053C is not an essential gene
Localization:
Intensity:
Fold change:
Significance:
-
C’ GFP library in SD

nucleus:cytosol23.51 -
N' NOP1pr-GFP in SD
nucleus49.5115 -
N' TEF2pr-mCherry in SD
nucleus43.9707 -
N' NATIVEpr-GFP in SD
nucleus29.3003 -
N' TEF2pr-VC and Cyto-VN in SD

nucleus37.2085 -
C’ GFP library in SD+DTT

nucleus.cytosol20.510.87No -
C’ GFP library in SD+H2O2

nucleus.cytosol17.810.75Yes -
C’ GFP library in Starvation Media
nucleus,cytosol22.610.96No -
C’ GFP library on the background of Pup2-DaMP

nucleus:cytosol -
C’ GFP library on the background of CCT mutant

nucleus:cytosol24.42481.03854No
